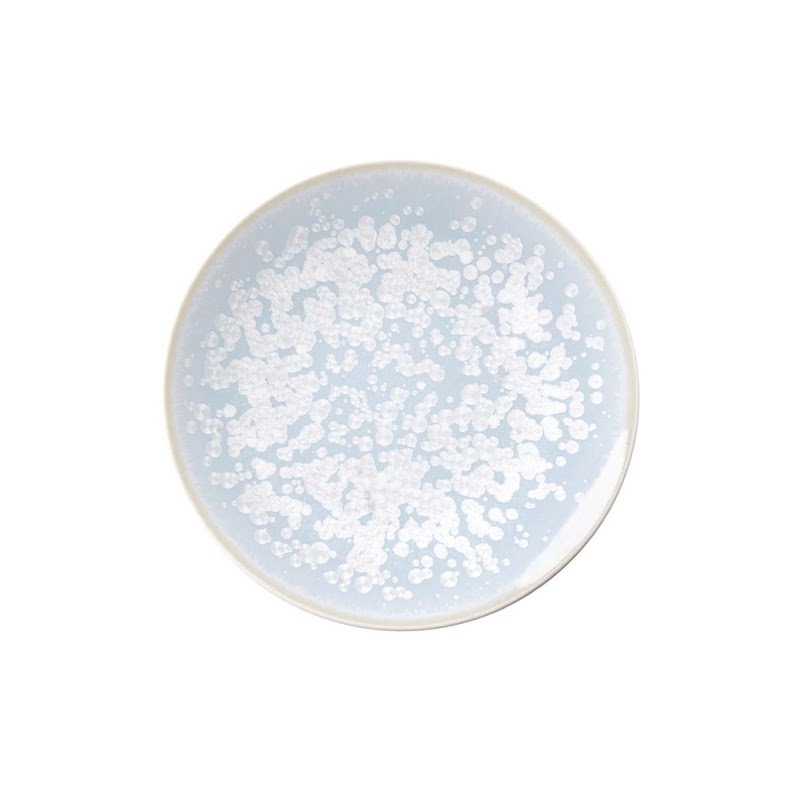

Song Ocean
by Jaune de Chrome
Handmade porcelain
Jaune de Chrome is known world-wide for their exclusive glaze craftsmanship: Metallic components blended with glaze are meticulously applied on porcelain, after which the magic of the firing process transfoms the raw materials. Each piece is unique, neither exactly the same, nor really different.
Without gold or platinum this set is suitable for the dishwasher and microwave
Because of the diversity and the extensive range of this collection only some of the items and an overview of the various shapes of this set are shown here. Kindly contact us for more information.
Delivery time 8 to 10 weeks
Jaune de Chrome is known world-wide for their exclusive glaze craftsmanship: Metallic components blended with glaze are meticulously applied on porcelain, after which the magic of the firing process transfoms the raw materials. Each piece is unique, neither exactly the same, nor really different.
Without gold or platinum this set is suitable for the dishwasher and microwave
Because of the diversity and the extensive range of this collection only some of the items and an overview of the various shapes of this set are shown here. Kindly contact us for more information.
Delivery time 8 to 10 weeks